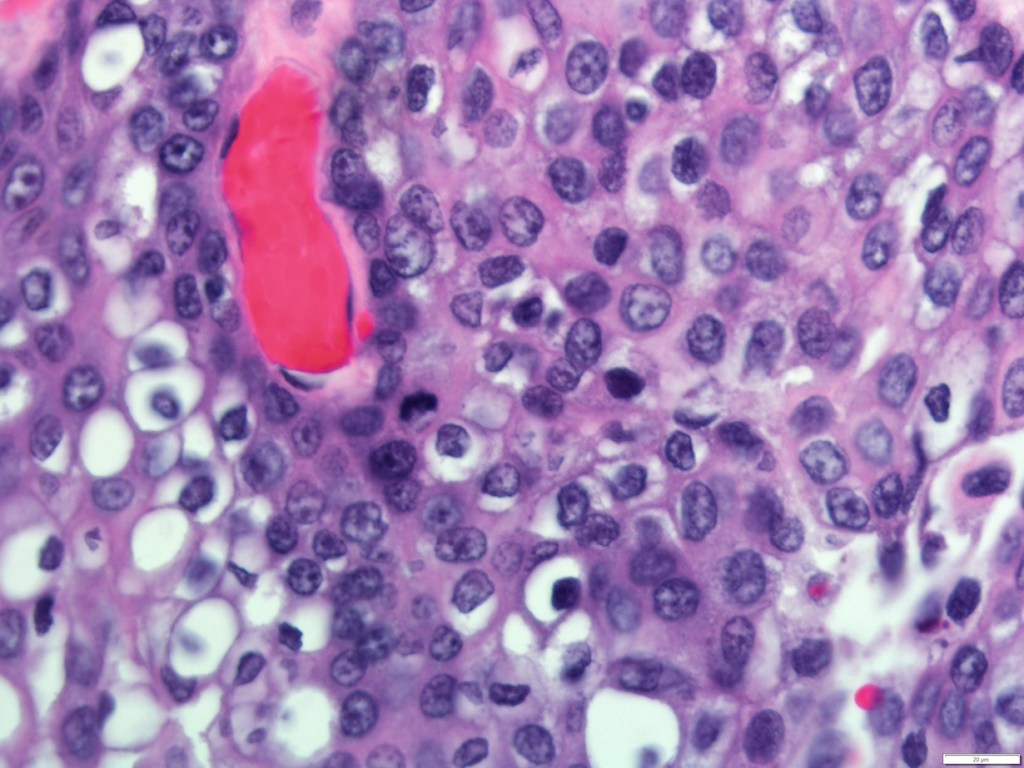

- Mucoepidermoid carcinoma (MEC):
- Is the most common malignant neoplasm of the:
- Mayor and minor salivary glands
- Is the most common malignant neoplasm of the:
- Epidemiology:
- They encompass between 2.8% to 15.5% of all salivary gland tumors
- Among 12% to 35% of malignant salivary gland tumors
- Among 6.5% to 41% of all minor salivary gland tumors:
- Representing the most common type of malignant minor salivary gland tumor in most series
- Approximately half the cases occur in the major salivary glands:
- 65% to 80% of these occur in the parotid
- 8% to 13% occur in the submandibular gland
- 2% to 4% involve the sublingual gland
- MEC of the minor salivary glands:
- Ordinarily arises on the palate:
- But a number may also be found in the:
- Retro molar area
- Floor of the mouth
- Buccal mucosa
- Lip
- Tongue
- But a number may also be found in the:
- Ordinarily arises on the palate:
- Its prevalence is highest in:
- The fourth to fifth decade of life (35 to 65 years of age):
- With a female preponderance as high as 4:1
- The fourth to fifth decade of life (35 to 65 years of age):
- Grossly:
- The tumor is poorly circumscribed and measures from 3 to 5 cm
- Histologically:
- They are characterized by a mixed population of cells, including:
- Mucin-producing cells
- Epidermoid cells with squamoid differentiation
- Clear cells
- Intermediate cells:
- That may predominate in numbers
- Are believed to be the progenitor of the other types of cells
- No myoepithelial cells are present
- They are characterized by a mixed population of cells, including:
- The clinical behavior of MEC has proved to be difficult to predict:
- But correlations to tumor grade and stage have been reported
- The histologic features that are most useful in predicting the aggressive nature of these tumors are:
- A minor cystic component (less than 20%)
- Tumor necrosis
- Neural invasion
- Cellular anaplasia
- Brisk mitotic activity
- Based on the presence or absence of these features and the clinical behavior, MEC are classified as:
- Low grade
- Intermediate grade
- High grade
- Low-grade MEC are:
- Well circumscribed, with pushing margins and dilated cystic areas containing mucin
- Mucin producing, intermediate, or epidermoid cells make up the lining of these cystic structures
- Intermediate-grade MEC:
- As the grade worsens:
- The tumors become more infiltrative, poorly circumscribed
- Cystic formations are lost
- Nests of tumor become more solid and irregular with intermediate or epidermoid cells dominating
- As the grade worsens:
- High-grade MEC are characterized by:
- The invasion of adjacent structures
- Atypical mitoses
- Necrosis
- Perineural invasion
- Lymph node metastasis:
- 40% to 50%
- Distant metastases
- Differential diagnosis of these high-grade lesions are:
- Primary of metastatic squamous cell carcinoma:
- MEC is differentiated from metastatic SCC by:
- The presence of intracellular mucin
- MEC is differentiated from metastatic SCC by:
- Sebaceous carcinomas
- Clear cell carcinomas
- Primary of metastatic squamous cell carcinoma:
- Histologic grade and tumor stage:
- Appear to have profound effects on survival
- Aro et al:
- Found a statistically significant difference in disease free survival (DFS) by grade:
- Between low-grade MEC and intermediate / high-grade MEC (P = 0.001)
- Found a statistically significant difference in disease free survival (DFS) by grade:

#Arrangoiz #CancerSurgeon #HeadandNeckSurgeon #SurgicalOncologist #SalivaryGlandCancer #MucoepidermoidCarcinoma #ParotidTumors #MEC #CASO #CenterforAdvancedSurgicalOncology #Miami
